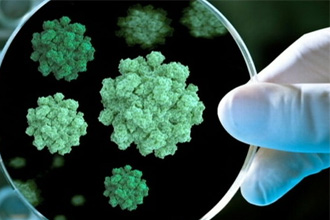
Что такое кишечный грипп? Что такое кишечный грипп?

Понос является довольно частым симптомом инфекционного поражения вирусом желудочно-кишечного тракта. Такого рода заболевание встречается, как у взрослых, так и у детей. Однако стоит обратить внимание, что проявление в виде диареи может приводить к обезвоживанию организма, поэтому требует медикаментозной терапии. В статье разберемся с основными признаками, диагностикой и лечением болезни.
Причины кишечного гриппа
Инфекция попадает в организм человека тремя основными путями:
- фекально-оральный;
- воздушно-капельный;
- контактно-бытовой.
Первым из них является фекально-оральный механизм – вирус передается через немытые руки, употребление грязных овощей и фруктов, некипяченой воды, купание в зараженных водоемах (реки, моря, озера). Также заболевание может распространяться воздушно-капельно – во время кашля, чихания, поцелуев и т.д. При заражении контактно-бытовым путем наблюдается использование одних полотенец, столовых приборов, чашек вместе с больным. Пик заболеваемости ротавирусной инфекцией приходится на весенне-летний период времени, чаще всего заражение происходит на пляже.
Входными воротами для инфекции являются слизистые оболочки организма. Инкубационный период может продолжаться от нескольких часов до 5 дней, в зависимости от состояния иммунной системы человека.

Врачи отмечают, что понос при гриппе может быть одним из проявлений вирусной инфекции. Основные признаки включают частые жидкие стулы, боли в животе и общее недомогание. Важно понимать, что такие симптомы могут возникать из-за воздействия вируса на желудочно-кишечный тракт, а также из-за сопутствующих факторов, таких как высокая температура и обезвоживание.
Лечение поноса при гриппе в первую очередь направлено на восстановление водно-электролитного баланса. Врачи рекомендуют пить много жидкости, включая специальные растворы для регидратации. В некоторых случаях могут быть назначены пробиотики для восстановления микрофлоры кишечника. Однако применение противодиарейных средств без консультации специалиста не рекомендуется, так как это может усугубить состояние. Важно следить за общим состоянием пациента и при ухудшении обращаться за медицинской помощью.
Симптомы
Так как причиной возникновения заболевания является вирус, поражающий весь организм, то болезнь не ограничивается проявлениями только со стороны желудочно-кишечного тракта.
Дети переносят инфекцию намного тяжелее. У взрослых заболевание может протекать бессимптомно или с незначительными проявлениями, на которые, как правило, больной не обращает внимания.
Основными признаками при кишечной вирусной инфекции являются:
- покраснение конъюнктивы глаз;
- чихание, кашель;
- заложенность носа;
- покраснение горла;
- бледность кожных покровов;
- общее недомогание, слабость;
- боль и першение в горле;
- повышенная температура тела, озноб;
- потеря аппетита;
- боли в животе;
- тошнота;
- рвота;
- частый жидкий стул;
- сонливость.

Распространенной ошибкой пациентов является прием антидиарейных и противорвотных препаратов при первых признаках болезни, принимая ее за банальное пищевое отравление.
Это приводит к смазыванию симптоматики со стороны ЖКТ, но не лечит саму причину заболевания. В этом случае, по-прежнему, сохраняются общая слабость, недомогание, повышение температуры тела, проявления со стороны верхних дыхательных путей.
Диарея при гриппе у взрослых обычно характеризуется резким неприятным запахом, серо-желтым цветом испражнений, напоминающих глину по консистенции. При этом не наблюдается прослоек крови, слизи и других примесей в кале.
Механизм развития диареи при гриппе
Попадая в организм человека, вирус проникает через слизистую кишечника, разрушая при этом эпителиальные клетки. В связи с чем, нарушается ферментативная функция желез и всасывание различных веществ и воды. В просвете кишки скапливаются сложные сахара, из-за которых очень быстро активизируются процессы брожения.
Эти изменения способствуют раздражению стенки кишечника и, как следствие, усиливается перистальтика и наблюдается жидкий стул.
В отличие от пищевого отравления, понос при гриппе может продолжаться даже после полного очищения кишечника, что приводит к быстрому обезвоживанию организма.

Понос при гриппе — это симптом, который вызывает беспокойство у многих. Люди отмечают, что он может проявляться как следствие вирусной инфекции, когда организм пытается избавиться от токсинов. Основные признаки включают частые водянистые испражнения, боли в животе и общее недомогание. Некоторые пациенты сообщают о сочетании поноса с другими симптомами гриппа, такими как высокая температура и кашель.
Лечение обычно включает поддержание водного баланса, так как обезвоживание может стать серьезной проблемой. Рекомендуется пить много жидкости, включая электролитные растворы. В некоторых случаях врачи советуют использовать пробиотики для восстановления микрофлоры кишечника. Однако важно помнить, что самолечение может быть опасным, и при появлении таких симптомов лучше обратиться к врачу для получения квалифицированной помощи.
Осложнения
Несвоевременное обращение за медицинской помощью с диареей при гриппе может быть чревато появлением осложнений заболевания. Из-за довольно быстро развивающегося обезвоживания нарушается работа сердца, органов дыхания, почек, печени.
За счет быстрых механизмов передачи и непродолжительному инкубационному периоду болезнь стремительно разрастается до масштабов эпидемии.
Диарея при гриппе у детей из-за меньшего объема циркулирующей крови, чем у взрослых, способна за считанные часы вызвать дегидратацию организма тяжелой степени. У грудничков развитие такого состояния может привести к летальному исходу. Кроме того, неправильное или несвоевременно начатое лечение заболевания провоцирует обострение имеющихся у больного хронических патологий.
Диагностика
Диагностика заболевания должна проводиться только врачом на основании жалоб пациента, данных анамнеза болезни и жизни, объективного осмотра, лабораторных и инструментальных методов исследования.
В обязательный перечень диагностики входят:
- общий анализ крови и мочи (обнаруживается снижение уровня лейкоцитов с относительным лимфоцитозом, повышенная скорость оседания эритроцитов, может наблюдаться анемия);
- биохимический анализ крови (проводится оценка уровня печеночных проб, глюкозы, амилазы, общего белка, электролитов);
копрограмма (анализ кала является обязательным, помогает исключить патологию, непосредственно связанную с органами желудочно-кишечного тракта);
- посев кала на флору (исключает наличие бактериальной кишечной инфекции, такой как сальмонеллез, холера, пищевое отравление, вызванное стафилококком или спровоцированными простейшими – амебиаз, лямблиоз);
- ультразвуковое исследование органов брюшной полости;
- электрокардиограмма – применяется для оценки состояния сердечно-сосудистой системы при обезвоживании организма.
Лечение
Терапию диареи при гриппе целесообразно проводить в условиях стационара, так как только врач может оценить тяжесть состояния и степень обезвоживания организма. Больному обязательно назначается постельный режим и обильное питье во время всего острого периода заболевания.
Медикаментозная терапия
Основным в лечении кишечного гриппа является симптоматическая терапия, которая включает в себя:
- восполнение объема циркулирующей крови за счет обильного питья и/или парентерального введения солевых растворов;
- противорвотное лекарство;
- антидиарейный препарат;
- жаропонижающие средства для снижения температуры тела.
В случаях неэффективности вышеперечисленных препаратов рекомендуется назначение Интерферона – противовирусного средства, стимулирующего работу иммунной системы и препятствующего дальнейшему проникновению инфекции в клетки организма.
При данном заболевании категорически запрещены кишечные антибиотики. Прием этих препаратов уничтожит нормальную микрофлору и приведет к ухудшению состояния.
Диета
Лечебное питание является одной из составляющих эффективной терапии гриппа, сопровождающегося поносом. В период острых проявлений заболевания следует воздержаться от приема пищи, таким образом, уменьшая нагрузку на желудочно-кишечный тракт.
В дальнейшем соблюдается строгая диета. Из рациона исключаются жаренные, копченные, пряные, жирные блюда. Разрешены овощные и легкие мясные бульоны. Больному предлагают разнообразить свою диету нежирным мясом или рыбой, приготовленными на пару, запеченными или сваренными. Не ограничено употребление овощей, кисломолочной продукции, фруктов. Из напитков допускаются компоты, некрепкий чай, минеральная вода без газа, соки.
Пациент должен придерживаться диеты на протяжении нескольких недель после перенесенного заболевания. В период выздоровления врач обычно назначает прием ферментных препаратов.
Профилактика
https://youtube.com/watch?v=xMmWrONW72A
Профилактика гриппа, сопровождающегося диареей, сводится к следующим принципам:
- мыть руки перед едой и после посещения мест общественного пользования;
- употреблять в пищу только хорошо вымытые овощи и фрукты;
- перед употреблением кипятить воду;
- регулярно проветривать квартиру;
- соблюдать правила личной гигиены (пользоваться индивидуальным полотенцем, столовыми приборами);
- принимать витамины и микроэлементы для усиления иммунной системы организма;
- закаляться;
- вести активный образ жизни, часто совершать пешие прогулки;
- стараться ограждать себя от стрессов;
- правильно и полноценно питаться.
Вопрос-ответ
Как понять, что вирусный понос?
Вирусная диарея обычно проявляется в виде водянистой (не кровянистой) диареи. Она может сопровождаться другими симптомами, такими как тошнота, спазмы в животе, рвота и лихорадка, что приводит к состоянию, известному как вирусный гастроэнтерит.
Каковы симптомы расстройства кишечника при вирусной инфекции?
Для вирусной диареи характерно сочетание расстройства стула с лихорадкой и диспепсией — ощущением тяжести, вздутием живота, отрыжкой, изжогой и тошнотой. При ротавирусной инфекции может наблюдаться поражение верхних дыхательных путей, то есть появление таких симптомов, как заложенность носа и боль в горле.
Советы
СОВЕТ №1
При первых признаках поноса, сопровождающего грипп, важно увеличить потребление жидкости. Это поможет предотвратить обезвоживание, которое может возникнуть из-за потери жидкости.
СОВЕТ №2
Следите за своим рационом. Избегайте жирной и острой пищи, отдавайте предпочтение легким и легко усваиваемым продуктам, таким как рис, бананы и тосты.
СОВЕТ №3
Обратитесь к врачу, если понос продолжается более 48 часов или сопровождается высокой температурой, сильной болью в животе или кровью в стуле. Это может быть признаком более серьезного состояния.
копрограмма (анализ кала является обязательным, помогает исключить патологию, непосредственно связанную с органами желудочно-кишечного тракта);
